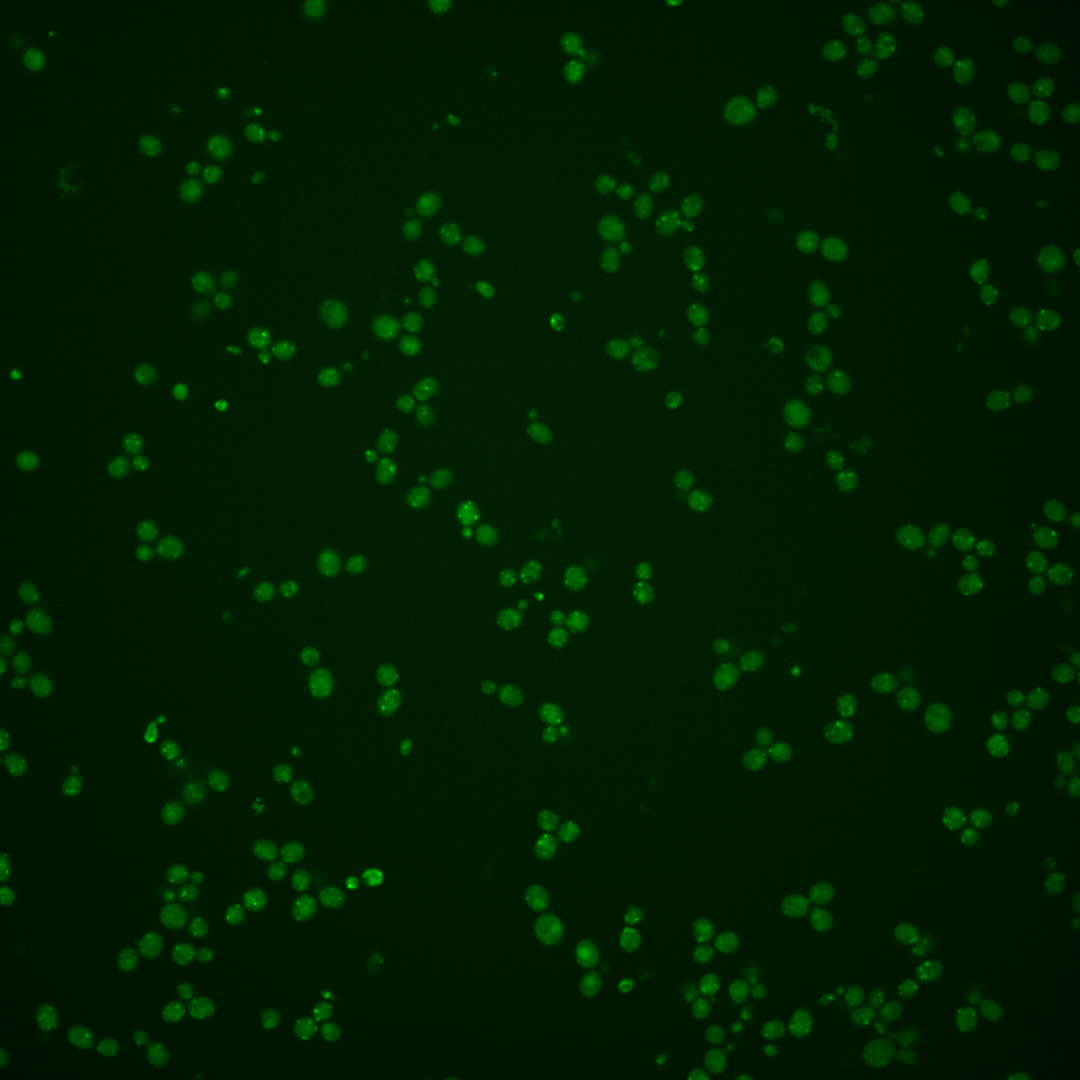

| Standard name | |
|---|---|
| Human Ortholog | |
| Description | Cu(+2)-transporting P-type ATPase; required for export of copper from the cytosol into an extracytosolic compartment; similar to human proteins involved in Menkes and Wilsons diseases; protein abundance increases in response to DNA replication stress; affects TBSV model (+)RNA virus replication by regulating copper metabolism; human homologs ATP7A and ATP7B both complement yeast null mutant |
Micrographs




















































































Sub-cellular Localization
Yeast GFP Assignment
Protein Abundance
Localization Change
External localization resources
| ensLOC | DeepLoc | |||||||||||||||||||||||
|---|---|---|---|---|---|---|---|---|---|---|---|---|---|---|---|---|---|---|---|---|---|---|---|---|
| Localization | WT1 | WT2 | WT3 | RAP60 | RAP140 | RAP220 | RAP300 | RAP380 | RAP460 | RAP540 | RAP620 | RAP700 | HU80 | HU120 | HU160 | rpd3Δ_1 | rpd3Δ_2 | rpd3Δ_3 | WT1 | WT2 | WT3 | AF100 | AF140 | AF180 |
| Cortical Patches | 10 | 6 | 1 | 1 | 1 | 0 | 2 | 2 | 2 | 0 | 4 | 0 | 5 | 6 | 2 | 3 | 2 | 2 | 2 | 1 | 7 | 1 | 2 | 3 |
| Bud | 2 | 1 | 7 | 2 | 7 | 6 | 16 | 34 | 18 | 23 | 20 | 22 | 0 | 1 | 0 | 2 | 3 | 2 | 1 | 0 | 0 | 0 | 1 | 1 |
| Bud Neck | 0 | 0 | 0 | 0 | 0 | 0 | 0 | 1 | 0 | 0 | 0 | 0 | 0 | 0 | 0 | 0 | 0 | 0 | 0 | 0 | 0 | 0 | 0 | 0 |
| Bud Site | 0 | 0 | 0 | 0 | 0 | 1 | 1 | 0 | 0 | 1 | 1 | 1 | 0 | 0 | 0 | 0 | 0 | 0 | – | – | – | – | – | – |
| Cell Periphery | 0 | 0 | 0 | 1 | 0 | 0 | 1 | 2 | 1 | 0 | 0 | 1 | 0 | 0 | 0 | 1 | 1 | 0 | 0 | 0 | 0 | 0 | 0 | 0 |
| Cytoplasm | 153 | 57 | 62 | 44 | 130 | 202 | 287 | 308 | 192 | 262 | 188 | 247 | 2 | 13 | 13 | 175 | 150 | 72 | 14 | 8 | 1 | 4 | 7 | 11 |
| Endoplasmic Reticulum | 14 | 12 | 6 | 3 | 2 | 5 | 2 | 3 | 1 | 4 | 1 | 5 | 8 | 3 | 11 | 23 | 34 | 19 | 3 | 0 | 1 | 4 | 5 | 3 |
| Endosome | 87 | 1 | 100 | 88 | 129 | 56 | 135 | 169 | 49 | 14 | 20 | 42 | 7 | 11 | 17 | 93 | 130 | 71 | 153 | 38 | 153 | 55 | 46 | 41 |
| Golgi | 2 | 0 | 13 | 5 | 1 | 1 | 0 | 0 | 1 | 0 | 0 | 0 | 5 | 33 | 61 | 5 | 16 | 22 | 59 | 12 | 79 | 24 | 13 | 16 |
| Mitochondria | 40 | 75 | 100 | 63 | 62 | 148 | 202 | 248 | 180 | 290 | 162 | 195 | 18 | 19 | 5 | 42 | 49 | 25 | 81 | 41 | 32 | 40 | 39 | 37 |
| Nucleus | 1 | 0 | 1 | 0 | 0 | 1 | 1 | 6 | 2 | 2 | 1 | 2 | 0 | 1 | 0 | 11 | 16 | 9 | 0 | 0 | 0 | 0 | 0 | 0 |
| Nuclear Periphery | 0 | 3 | 0 | 0 | 0 | 0 | 2 | 7 | 1 | 4 | 2 | 2 | 2 | 0 | 1 | 3 | 1 | 2 | 1 | 0 | 0 | 0 | 0 | 1 |
| Nucleolus | 1 | 1 | 4 | 1 | 1 | 2 | 6 | 21 | 3 | 3 | 0 | 1 | 3 | 4 | 0 | 4 | 3 | 4 | 0 | 0 | 0 | 0 | 0 | 0 |
| Peroxisomes | 1 | 0 | 8 | 4 | 7 | 2 | 8 | 9 | 2 | 2 | 2 | 2 | 0 | 0 | 0 | 1 | 2 | 1 | 2 | 1 | 12 | 1 | 1 | 0 |
| SpindlePole | 12 | 1 | 13 | 8 | 3 | 8 | 16 | 37 | 8 | 8 | 6 | 14 | 2 | 2 | 1 | 24 | 7 | 8 | 4 | 0 | 2 | 2 | 1 | 2 |
| Vac/Vac Membrane | 145 | 37 | 76 | 44 | 153 | 105 | 172 | 144 | 64 | 112 | 65 | 84 | 6 | 40 | 109 | 386 | 488 | 343 | 180 | 70 | 63 | 77 | 89 | 99 |
| Unique Cell Count | 395 | 146 | 302 | 203 | 383 | 455 | 655 | 781 | 418 | 572 | 383 | 491 | 37 | 92 | 178 | 587 | 721 | 465 | 509 | 180 | 360 | 216 | 211 | 221 |
| Labelled Cell Count | 468 | 194 | 391 | 264 | 496 | 537 | 851 | 991 | 524 | 725 | 472 | 618 | 58 | 133 | 220 | 773 | 902 | 580 | 509 | 180 | 360 | 216 | 211 | 221 |
Yeast GFP Assignment
Protein Abundance
| Screen | WT1 | WT2 | WT3 | RAP60 | RAP140 | RAP220 | RAP300 | RAP380 | RAP460 | RAP540 | RAP620 | RAP700 | HU80 | HU120 | HU160 | rpd3Δ_1 | rpd3Δ_2 | rpd3Δ_3 | AF100 | AF140 | AF180 |
|---|---|---|---|---|---|---|---|---|---|---|---|---|---|---|---|---|---|---|---|---|---|
| Mean Cell GFP Intensity (1e-4) | 5.5 | 4.9 | 5.6 | 5.6 | 5.6 | 4.8 | 4.7 | 4.9 | 4.9 | 4.3 | 4.7 | 4.5 | 7.7 | 9.3 | 10.7 | 6.4 | 7.6 | 9.3 | 6.6 | 6.7 | 7.3 |
| Std Deviation (1e-4) | 0.8 | 0.9 | 1.4 | 1.3 | 1.8 | 1.2 | 1.2 | 1.2 | 1.4 | 1.1 | 1.4 | 1.0 | 1.6 | 1.8 | 1.5 | 1.4 | 1.7 | 2.2 | 1.3 | 1.6 | 2.2 |
| Intensity Change (Log2) | – | – | – | -0.01 | 0.01 | -0.23 | -0.26 | -0.19 | -0.21 | -0.4 | -0.27 | -0.32 | 0.45 | 0.73 | 0.93 | 0.18 | 0.44 | 0.72 | 0.24 | 0.26 | 0.38 |
Localization Change
| Localization | RAP60 | RAP140 | RAP220 | RAP300 | RAP380 | RAP460 | RAP540 | RAP620 | RAP700 | HU80 | HU120 | HU160 | rpd3Δ_1 | rpd3Δ_2 | rpd3Δ_3 |
|---|---|---|---|---|---|---|---|---|---|---|---|---|---|---|---|
| Actin | – | – | – | – | – | – | – | – | – | – | – | – | – | – | – |
| Bud | – | – | – | – | – | – | – | – | – | – | – | – | 0 | 0 | 0 |
| Bud Neck | – | – | – | – | – | – | – | – | – | – | – | – | 0 | 0 | 0 |
| Bud Site | – | – | – | – | – | – | – | – | – | – | – | – | 0 | 0 | 0 |
| Cell Periphery | – | – | – | – | – | – | – | – | – | – | – | – | 0 | 0 | 0 |
| Cyto | – | – | – | – | – | – | – | – | – | – | – | – | – | – | – |
| Endoplasmic Reticulum | – | – | – | – | – | – | – | – | – | – | – | – | 0 | 0 | 0 |
| Endosome | – | – | – | – | – | – | – | – | – | – | – | – | 0 | 0 | 0 |
| Golgi | – | – | – | – | – | – | – | – | – | – | – | – | 0 | 0 | 0 |
| Mitochondria | – | – | – | – | – | – | – | – | – | – | – | – | 0 | 0 | 0 |
| Nuclear Periphery | – | – | – | – | – | – | – | – | – | – | – | – | 0 | 0 | 0 |
| Nuc | – | – | – | – | – | – | – | – | – | – | – | – | – | – | – |
| Nucleolus | – | – | – | – | – | – | – | – | – | – | – | – | 0 | 0 | 0 |
| Peroxisomes | – | – | – | – | – | – | – | – | – | – | – | – | 0 | 0 | 0 |
| SpindlePole | – | – | – | – | – | – | – | – | – | – | – | – | 0 | 0 | 0 |
| Vac | – | – | – | – | – | – | – | – | – | – | – | – | – | – | – |
| Cortical Patches | – | – | – | – | – | – | – | – | – | – | – | – | 0 | 0 | 0 |
| Cytoplasm | – | – | – | – | – | – | – | – | – | – | – | – | 0 | 0 | 0 |
| Nucleus | – | – | – | – | – | – | – | – | – | – | – | – | 0 | 0 | 0 |
| Vacuole | – | – | – | – | – | – | – | – | – | – | – | – | 11.5 | 12.5 | 13.2 |
External localization resources
Images






























Protein Concentration and Protein Localization Data
| R1 | R2 | R3 | ||||||||||||||||
|---|---|---|---|---|---|---|---|---|---|---|---|---|---|---|---|---|---|---|
| G1 Pre-START | G1 Post-START | S/G2 | Metaphase | Anaphase | Telophase | G1 Pre-START | G1 Post-START | S/G2 | Metaphase | Anaphase | Telophase | G1 Pre-START | G1 Post-START | S/G2 | Metaphase | Anaphase | Telophase | |
| Concentration | – | – | – | – | – | – | – | – | – | – | – | – | – | – | – | – | – | – |
| Actin | 0.0469 | 0.0014 | 0.0023 | 0.002 | 0.0091 | 0.0014 | 0.0006 | 0.0002 | 0.0024 | 0.0011 | 0.0305 | 0.0011 | – | – | – | – | – | – |
| Bud | 0.0013 | 0.0012 | 0.0004 | 0.0006 | 0.0006 | 0.0003 | 0.0002 | 0.0006 | 0.0003 | 0.0002 | 0.0005 | 0.0004 | – | – | – | – | – | – |
| Bud Neck | 0.0019 | 0.0018 | 0.0017 | 0.0009 | 0.001 | 0.0009 | 0.0004 | 0.0004 | 0.0032 | 0.0003 | 0.0004 | 0.0005 | – | – | – | – | – | – |
| Bud Periphery | 0.0029 | 0.001 | 0.0004 | 0.0005 | 0.001 | 0.0005 | 0.0003 | 0.0008 | 0.0005 | 0.0002 | 0.0006 | 0.0008 | – | – | – | – | – | – |
| Bud Site | 0.004 | 0.0138 | 0.0081 | 0.0015 | 0.0042 | 0.0003 | 0.001 | 0.0021 | 0.0025 | 0.0004 | 0.0022 | 0.0003 | – | – | – | – | – | – |
| Cell Periphery | 0.0006 | 0.0007 | 0.0002 | 0.0001 | 0.0004 | 0.0002 | 0.0002 | 0.0007 | 0.0003 | 0.0001 | 0.0001 | 0.0002 | – | – | – | – | – | – |
| Cytoplasm | 0.0169 | 0.0414 | 0.016 | 0.0144 | 0.0109 | 0.0156 | 0.0118 | 0.0131 | 0.0351 | 0.0075 | 0.0015 | 0.0057 | – | – | – | – | – | – |
| Cytoplasmic Foci | 0.0391 | 0.0429 | 0.0418 | 0.0448 | 0.0364 | 0.0385 | 0.0651 | 0.0451 | 0.0703 | 0.0473 | 0.0458 | 0.0245 | – | – | – | – | – | – |
| Eisosomes | 0.0005 | 0 | 0.0002 | 0 | 0.0003 | 0 | 0 | 0 | 0.0001 | 0 | 0.0002 | 0 | – | – | – | – | – | – |
| Endoplasmic Reticulum | 0.0109 | 0.0058 | 0.0026 | 0.002 | 0.0031 | 0.0051 | 0.0032 | 0.006 | 0.0043 | 0.001 | 0.0009 | 0.0038 | – | – | – | – | – | – |
| Endosome | 0.543 | 0.5525 | 0.5824 | 0.6515 | 0.5529 | 0.5538 | 0.5466 | 0.5826 | 0.5462 | 0.6217 | 0.5511 | 0.5477 | – | – | – | – | – | – |
| Golgi | 0.0833 | 0.0693 | 0.0732 | 0.0479 | 0.0856 | 0.0769 | 0.1192 | 0.0929 | 0.1131 | 0.0839 | 0.1788 | 0.1488 | – | – | – | – | – | – |
| Lipid Particles | 0.0352 | 0.0114 | 0.0151 | 0.0044 | 0.0239 | 0.0076 | 0.023 | 0.0094 | 0.0161 | 0.0247 | 0.0113 | 0.0097 | – | – | – | – | – | – |
| Mitochondria | 0.024 | 0.0167 | 0.0172 | 0.0399 | 0.0992 | 0.0182 | 0.0435 | 0.0336 | 0.0596 | 0.0442 | 0.0669 | 0.0283 | – | – | – | – | – | – |
| None | 0.0319 | 0.0045 | 0.0116 | 0.001 | 0.0027 | 0.0038 | 0.0381 | 0.007 | 0.0288 | 0.0002 | 0.0002 | 0.0179 | – | – | – | – | – | – |
| Nuclear Periphery | 0.0185 | 0.0047 | 0.0023 | 0.0026 | 0.0047 | 0.0041 | 0.0039 | 0.0034 | 0.003 | 0.0012 | 0.0006 | 0.0051 | – | – | – | – | – | – |
| Nucleolus | 0.0022 | 0.0003 | 0.0004 | 0.0002 | 0.0008 | 0.0004 | 0.0014 | 0.0006 | 0.0009 | 0.0001 | 0.0001 | 0.0002 | – | – | – | – | – | – |
| Nucleus | 0.0117 | 0.0012 | 0.0007 | 0.0009 | 0.0027 | 0.001 | 0.0013 | 0.001 | 0.0016 | 0.0003 | 0.0002 | 0.0006 | – | – | – | – | – | – |
| Peroxisomes | 0.0087 | 0.0013 | 0.0113 | 0.005 | 0.0082 | 0.0027 | 0.003 | 0.003 | 0.0054 | 0.0056 | 0.0055 | 0.0051 | – | – | – | – | – | – |
| Punctate Nuclear | 0.0108 | 0.0005 | 0.0031 | 0.0003 | 0.0013 | 0.0022 | 0.0525 | 0.0002 | 0.0013 | 0.0001 | 0.0001 | 0.0003 | – | – | – | – | – | – |
| Vacuole | 0.0753 | 0.1605 | 0.1357 | 0.1147 | 0.1227 | 0.1777 | 0.0384 | 0.1169 | 0.0667 | 0.1029 | 0.0746 | 0.1137 | – | – | – | – | – | – |
| Vacuole Periphery | 0.0304 | 0.067 | 0.0735 | 0.0647 | 0.0283 | 0.089 | 0.0461 | 0.0806 | 0.0383 | 0.0571 | 0.0278 | 0.0852 | – | – | – | – | – | – |
Sequencing Data
| R1 | R2 | |||||||||
|---|---|---|---|---|---|---|---|---|---|---|
| G1 Post-START | S/G2 | Metaphase | Anaphase | Telophase | G1 Post-START | S/G2 | Metaphase | Anaphase | Telophase | |
| Gene Expression | 12.0771 | 16.0307 | 18.4501 | 19.6454 | 8.7782 | 24.5065 | 39.3637 | 40.2983 | 41.8377 | 40.6843 |
| Translational Efficiency | 0.9629 | 0.9036 | 0.6492 | 0.6464 | 0.6123 | 0.6583 | 0.7188 | 0.5978 | 0.5464 | 0.5741 |
Hit Data
| Dataset | Hit |
|---|---|
| Protein Concentration | – |
| Protein Localization | ✘ |
| Gene Expression | ✔ |
| Translational Efficiency | ✘ |
Endocytosis
| Temp | Actin Patch (Sac6-tdTomato) | Cortical Patch (Sla1-GFP) | Late Endosome (Snf7-GFP) | Vacuole (Vph1-GFP) |
|---|---|---|---|---|
| 37℃ | ||||
| RT |
Cell Cycle Omics
CYCLoPs (Ccc2-GFP)
| Gene / Allele | Actin Patch (Sac6-tdTomato) | Cortical Patch (Sla1-GFP) | Late Endosome (Snf7-GFP) | Vacuole (Sac6-tdTomato) |
|---|
| Gene | Images |
|---|
| Gene | Images |
|---|
Images are not yet available
Images are not yet available